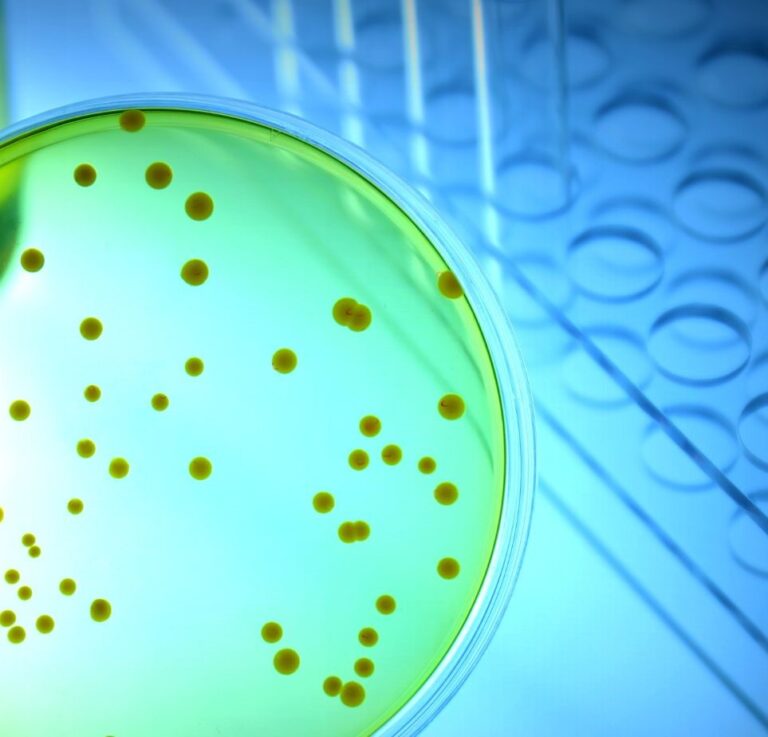
Test wydechowy wodorowo metanowy SIBO, IMO

Dietetyka

Każdego dnia, dokonując wyborów żywieniowych wpływamy na samopoczucie.
Sprawdź swoje parametry
Przed wizytą u dietetyka możesz zrobić samodzielnie pomiary: BMI i WHR. W tym celu zmierz swój wzrost, obwód w talii, w biodrach oraz skorzystaj z przeliczników:
Sekrety odżywiania w drodze do długowieczności

Umów się na wizytę
-

Konsultacja z dietetykiem
200 zł – 250 złZakres cen: od 200 zł do 250 złWybierz opcje Ten produkt ma wiele wariantów. Opcje można wybrać na stronie produktu -

Analiza niedoborów w organizmie - VIEVA
250 zł – 350 złZakres cen: od 250 zł do 350 złWybierz opcje Ten produkt ma wiele wariantów. Opcje można wybrać na stronie produktu
Program Metamorfoza
Program Metamorfoza w Holispace to zdrowa transformacja Twojego ciała. To uporządkowana, trzyfilarowa ścieżka redukcji masy ciała dla osób z nadwagą i otyłością, oparta na specjalistycznej opiece Instytutu Holispace.
Pierwszy filar stanowi dietetyk kliniczny, który prowadzi pacjenta od pierwszej konsultacji, poprzez analizę nawyków, wyników badań i stylu życia, aż do przygotowania indywidualnego planu żywienia dostosowanego do metabolizmu, aktywności i celów zdrowotnych.
Drugi filar to fizjoterapeuta, odpowiedzialny za bezpieczny i stopniowany program ćwiczeń dopasowany do możliwości pacjenta, ze wsparciem w zakresie poprawy mobilności, wydolności i pracy nad stabilizacją. Program obejmuje regularne sesje, monitoring postępów i comiesięczne analizy składu ciała.
Trzeci filar tworzą zabiegi modelujące sylwetkę z wykorzystaniem technologii High-Tech dostępnych w Holispace, które wspierają redukcję tkanki tłuszczowej, poprawę jędrności tkanek i pobudzanie mikrokrążenia. Dzięki precyzyjnym parametrom oraz indywidualnemu doborowi zabiegów wzmacniają one efekty dietoterapii i treningu, przyspieszając widoczne zmiany.
Dietetyk
Indywidualny plan żywienia dostosowany do metabolizmu, aktywności i celów zdrowotnych
Fizjoterapeuta
Bezpieczny program ćwiczeń dopasowany do możliwości, z monitoringiem postępów

Zabiegi HIGH-TECH
Modelujące sylwetkę, wspierające redukcję tkanki tłuszczowej i poprawę jędrności
Pakiet badań laboratoryjnych i ocena stanu zdrowia
Całość programu uzupełnia pakiet badań laboratoryjnych oraz ocena stanu zdrowia, które pozwalają ustalić optymalną drogę działania i sprawiają, że Metamorfoza jest procesem nie tylko skutecznym, ale przede wszystkim bezpiecznym. Ten trójstopniowy model – od żywienia przez ruch po technologię – tworzy jasną, przewidywalną i dopasowaną do pacjenta ścieżkę, prowadzącą do realnej i trwałej zmiany.
Zadzwoń by umówić się 15 minutową, darmową rozmowę on-line- by dowiedzieć się więcej o programie.
Nieinwazyjne badania i testy
Standardem w rozpoznaniu przyczyn dolegliwości są badania diagnostyczne, które obejmują podstawowe badania z materiału pacjenta (krew, mocz). W celu ustalenia zakresu badań, należy skontaktować się ze specjalistą.
Nauka opracowuje nowe możliwości w diagnostyce nieinwazyjnej o wysokiej czułości, wykonywane przez specjalistyczne jednostki laboratoryjne z zachowaniem standardu i procedur. Do takich należą: badania genetyczne mikrobiomu, skład bioty jelitowej.
Celem jest diagnostyka w kierunku dysbiozy i stan równowagi mikrobioty jelitowej. Badania nie są jeszcze złotym standardem w gastroenerologii, niosą jednak dużą wiedzę i wgląd w stan jelit pacjenta, z czego korzystają lekarze na całym świecie. W Instytucie Holispace dbamy o komplementarne podejście do analizy stanu zdrowia pacjenta, włączając możliwości jakie daje dziś nauka.